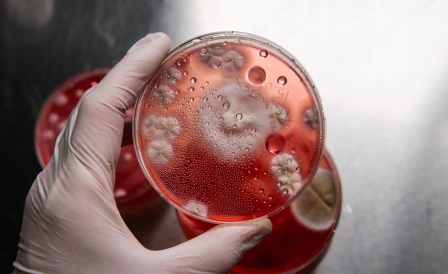
подробная картинка хламидиоза

Лучевая диагностика сердечно сосудистой системы это совокупность методов, которые дают «заглянуть» внутрь сердца и сосудов, получить детальное изображение их структуры и функции. Эти методы активно используются в кардиологии для исследований и мониторинга заболеваний. Благодаря лучевой диагностике кардиологи определяют причину болезни, ставят точный диагноз, выбирают действенный метод терапии, поддающийся дальнейшему контролю.
В медцентре лечения и оздоровления CHH оборудован диагностический центр, где можно провести необходимые исследования. Врач-кардиолог выслушает жалобы и проведет осмотр на приеме в клинике или приедет на дом по заранее заказанному вызову. Узнать подробнее можно по номеру на сайте.
Особенности диагностики
Лучевая диагностика сердечно сосудистой системы основана на применении ионизирующего излучения или ультразвука для получения изображений внутренних органов.
Первый метод лучевой диагностики в кардиологии — рентгенография. Исследование дает оценить размер органа, очертания камер, наличие изменений в легких и окружающих тканях, а также обнаружить некоторые пороки.
Ультразвуковую эхокардиографию используют, если нужно получить более детальную информацию о структуре сердца, его клапанах, толщине стенок миокарда, движении крови в камерах.
КТ и МРТ сердца позволяют получить полную информацию о работе сердца. КТ исследование делается с помощью рентгеновских лучей, а МРТ — с помощью магнитных волн и может иметь противопоказания. Методы позволяют выявить многие патологии: ишемическую болезнь, пороки сердца, кардиомиопатию, аневризму аорты.
Как подготовиться к процедуре
Подготовка к лучевой диагностике болезней сердца зависит от метода исследования. Перед рентгенографией грудной клетки потребуется снять все металлические предметы: украшения, часы, заколки. Это важно, потому что металл может исказить изображение на рентгеновском снимке.
Если вы носите брекеты, то нужно сообщить об этом медработнику перед процедурой, чтобы тот мог принять меры предосторожности и обеспечить качественное исследование. Например, область шеи и головы можно закрыть свинцовым фартуком.
К эхокардиографии специальная подготовка не требуется. Однако иногда кардиолог может рекомендовать принять легкий завтрак или обед перед исследованием, чтобы улучшить проводимость ультразвуковых волн.
Перед КТ и МРТ сердца нужно убрать все металлические предметы с себя, а также сообщить врачу о наличии аллергии на контрастные вещества, если их планируют использовать в ходе исследования. Иногда может потребоваться подготовка к КТ или МРТ, например, отказ от приема определенных лекарств за несколько дней до исследования.
В любом случае сообщите врачу о ваших заболеваниях и лекарствах, которые постоянно принимаете, а также аллергиях, чтобы врач подобрал безопасный, действенный метод диагностики и минимизировал возможные риски.
Основные этапы процесса
Лучевая диагностика болезней сердца проводится в специальном отделении, оборудованном современными аппаратами. Процесс контролируют квалифицированные специалисты.
Рентгенография грудной клетки — простой и быстрый метод. Пациент становится перед рентгеновским аппаратом, при этом удерживая дыхание в течение нескольких секунд, пока аппарат делает снимок.
Эхокардиография проводится ультразвуковым сканером, который посылает в сердце звуковые волны, а затем принимает их отражение. Пациент лежит на кушетке, к грудной клетке прикладывается датчик ультразвукового аппарата. Врач двигает датчиком по области груди, чтобы получить изображения сердца в разных проекциях.
КТ и МРТ — более сложные методы диагностики. Пациент лежит на специальном столе, который заезжает в туннель специального аппарата. Процесс исследования занимает от нескольких минут до часа, в зависимости от метода и области исследования. В процессе пациент должен сохранять неподвижность, чтобы изображения получились четкими.
После проведения лучевой диагностики врач анализирует полученные изображения и делает заключение о состоянии сердца и кровеносных сосудов. На основе этого заключения врач ставит диагноз и назначает лечение, если это необходимо.
Эффективность метода
Лучевая диагностика в кардиологии — безопасный и эффективный метод исследования сердца, выявляющий заболевания на ранней стадии. Преимущества такой диагностики:
- Точность — современные методы лучевой диагностики болезней сердца обладают высокой точностью, позволяя врачу получить четкие изображения структуры сердца и кровеносных сосудов.
- Низкая инвазивность — лучевая диагностика является неинвазивным методом, не требующим хирургического вмешательства.
- Безболезненность — большинство методов лучевой диагностики не вызывают никаких ощущений, лишь некоторые могут сопровождаться легким дискомфортом.
- Быстрое получение результатов — лучевая диагностика выдает результаты исследования в кратчайшие сроки, что важно для своевременной постановки диагноза и назначения лечения.
Лучевая диагностика остается фундаментальной частью сегодняшней кардиологии. Она позволяет не только определить причину сердечно-сосудистых заболеваний, но и назначить действенное лечение.
Современные методы лучевой диагностики, такие как рентгенография, эхокардиография, КТ и МРТ, обладают высокой точностью и безопасностью. Важно помнить о правильной подготовке к процедуре, ведь это позволит улучшить качество снимков и снизить риски.
Берегите здоровье и своевременно обращайтесь к врачу при первых же симптомах заболеваний сердца.
Вы можете обратиться для лечения тахикардии, звоните!

_448x674_854.webp)